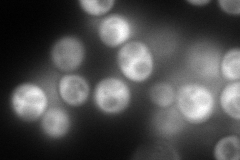
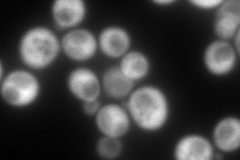
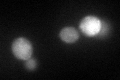
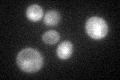

View description
Cysteine aminopeptidase with homocysteine-thiolactonase activity; protects cells against homocysteine toxicity; has bleomycin hydrolase activity in vitro; transcription is regulated by galactose via Gal4p; orthologous to human BLMH
Localization:
Intensity:
Fold change:
Significance:
-
C’ GFP library in SD

cytosol, mitochondria48.31 -
N' NOP1pr-GFP in SD
cytosol315.383 -
N' TEF2pr-mCherry in SD
cytosol337.41 -
N' NATIVEpr-GFP in SD

punctate30.2477 -
N' TEF2pr-VC and Cyto-VN in SD

#N/A0 -
C’ GFP library in SD+DTT
cytosol, mitochondria49.391.02No -
C’ GFP library in SD+H2O2

cytosol, mitochondria50.091.03No -
C’ GFP library in Starvation Media
nucleusN/AN/AYes -
C’ GFP library on the background of Pup2-DaMP

cytosol, mitochondria -
C’ GFP library on the background of CCT mutant

cytosol, mitochondria57.8341.19701No
